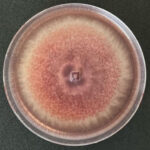
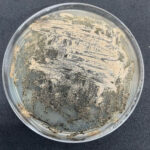
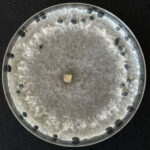
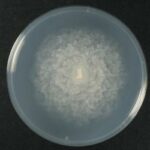
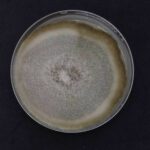
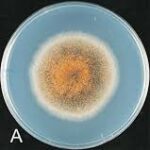
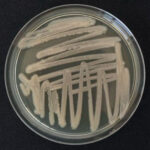

AG-Innova
Il laboratorio che accelera i tuoi progetti
Screening rapidi, dati affidabili, innovazione su misura. Tutto in un unico ecosistema sperimentale.
screening di laboratorio
Dalla formulazione alla validazione: un servizio completo e personalizzato
Per molti dei nostri progetti mettiamo a disposizione il nostro laboratorio interno. È qui che facciamo innovazione applicata, con analisi, test e ricerca.
Avere un laboratorio interno ti consente di: accorciare i tempi, aumentare il controllo e la garanzia del risultato, avere un servizio più completo e personalizzato, dalla scelta della formulazione/dosaggio iniziale fino alle fasi di test in campo.
Garanzia di risultato
Operando in condizioni controllate, con inoculi artificiali e con materiale vegetale sano e non trattato, garantiamo risultati affidabili riducendo al minimo le variabili esterne (biotiche e abiotiche).
Ottimizzazione risorse
Con più dati iniziali su prodotto, dose e tempi di applicazione, si impostano meglio le prove in campo, risparmiando risorse in termini di tempo e budget.
Efficienza tutto l’anno
Massima flessibilità perché i test sono programmabili tutto l’anno.
Entomologia e parassitologia
Insetti e parassiti per l’Agricoltura
Facciamo sperimentazione e ricerca su insetti fitofagi ed infestanti, entomofagi ed impollinatori, per eseguire in modo affidabile test di efficacia, biocontrollo e selettività.
- Test in ambienti con temperatura e umidità controllate
- Protocolli che garantiscono la qualità
- Metodi IRAC
Gli insetti fitofagi si sviluppano a spese degli organismi vegetali e possono provocare gravi danni alle colture agricole.
Il nostro lavoro si concentra sulle specie più dannose, che alleviamo e studiamo in condizioni ottimali.
I nostri allevamenti:

Spodoptera littoralis
Nottua del cotone

Tuta absoluta (popolazioni sensibili e resistenti)
Tignola del pomodoro

Bemisia tabaci (popolazioni sensibili e resistenti)
Mosca bianca del tabacco

Aphis gossypii
Afide del cotone e delle cucurbitacee

Myzus persicae (popolazioni sensibili e resistenti)
Afide verde del pesco

Nezara viridula
Cimice verde
Altri allevamenti disponibili:

Halyomorpha halys
Cimice asiatica

Helicoverpa armigera
Nottua gialla del pomodoro

Spodoptera exigua
Nottua piccola

Drosophila suzukii
Moscerino dei piccoli frutti

Xylosandrus compactus
Scolitide dell'alloro e del carrubo

Ceratitis capitata
Mosca mediterranea della frutta

Bactrocera oleae
Mosca dell'olivo

Pieris brassicae
Cavolaia maggiore

Altri su richiesta
ContattaciProve possibili: Test di efficacia, Knock-down test, Persistenza, Semi-campo, Mixing test, Resistenza, Choice test.
Sono organismi che possono infestare i magazzini di conservazione delle derrate alimentari e gli ambienti urbani e domestici.
Alcuni esempi:

Sitophilus spp.
Calandra dei cereali

Plodia interpunctella
Tignola fasciata delle derrate

Rhyzopertha dominica
Cappuccino dei cereali

Blatta orientalis
Blatta orientale

Periplaneta americana
Blatta americana

Blattella germanica
Blatta germanica

Musca domestica
Mosca domestica

Altri su richiesta
ContattaciProve possibili: Test di efficacia, Knock-down test, Persistenza, Mixing test, Resistenza, Choice test, Test Biocidi
Organismi benefici coinvolti nel controllo biologico e nell’impollinazione.
Vista la crescente importanza della tutela della biodiversità, eseguiamo test di selettività su:
Impollinatori
(Api, Bombi, ecc)
Entomofagi
(Predatori e Parassitoidi)
Prove possibili: Selettività, Choice test, Side effects (Valutazione degli effetti di dosi subletali di una sostanza sulla biologia di un organismo non target)
Insetti non target utilizzati ai fini scientifici.
Hermetia illucens
(Mosca soldato)
Utilizzata nel progetto FIT-BASS, per la produzione di farine proteiche destinate all’acquacoltura.Eseguiamo test anche su altri organismi, oltre agli insetti, come ad esempio:
Acari fitofagi
(es Tetranichidi ed Eriofidi)
Aracnidi parassiti delle piante che si nutrono succhiando la linfa vegetale
Varroa destructor
parassita esterno che attacca le api mellifere
Lumache e Limacce
Molluschi che si nutrono di erbe e piante, causando danni significativi negli orti.
Fitopatologia e diagnostica
Le patologie vegetali
Collezione di funghi e batteri patogeni delle piante, che utilizziamo per testare i prodotti fitosanitari in laboratorio, semi-campo e come fonte di inoculo artificiale in pieno campo.
Grazie a questi ceppi certificati, possiamo eseguire prove affidabili, ripetibili e controllate, assicurando una distribuzione uniforme del patogeno per risultati scientificamente validi.
- Test affidabili e ripetibili
- Ceppi identificati e certificati
- Distribuzione uniforme del patogeno
Funghi

Phytophthora infestans
Peronospora della patata e del pomodoro

Plasmopara viticola
Peronospora della vite
Fusarium spp.
Fusariosi
Septoria tritici
Septoriosi del frumento

Penicillium spp.
Muffe grigio/verdi
Sclerotinia sclerotiorum
Marciume bianco

Botrytis cinerea
Muffa grigia
Pythium spp.
Marciume radicale da Pythium

Podosphaera spp.
Oidio
Alternaria spp.
Alternariosi

Verticillium dahliae
Verticillosi

Rhizoctonia spp.
Rizottoniosi
Colletotrichum spp.
Antracnosi

Altri su richiesta
ContattaciBatteri
Xanthomonas spp.

Pseudomonas spp.
Prove possibili in vitro e in vivo: Efficacia, Persistenza, Mixing test, Resistenza, Test degradazione/dilavamento.
Laboratorio Nematologico
Nematodi: i parassiti del suolo
Laboratorio nematologico specializzato nell’allevamento di nematodi per eseguire test mirati in vitro e in semicampo. Simuliamo condizioni reali o completamente controllate e valutiamo con precisione l’efficacia dei prodotti nei confronti di questi nematodi fitopatogeni. Inoltre, a supporto dei test, riusciamo a quantificare la carica nematica presente in un campione di suolo.
Prove possibili: Test di efficacia, Knock-down test, Persistenza, Semi-campo, Mixing test.
- Disponibilità più celere di dati
- Test in vitro e in semicampo
- Focus su efficacia e ripetibilità dei test
- Allevamento e inoculo
Sistema di fenotipizzazione
Misura il comportamento delle piante in tempo reale
Agrigeos è il primo centro in Italia con 144 unità attive
PlantArray® è un sistema di fenotipizzazione che consente di analizzare come le piante rispondono a diversi fattori ambientali, inclusi stress biotici e abiotici (patogeni tellurici, nematodi, siccità, salinità, etc.), oltre che all’applicazione di fertilizzanti, biostimolanti o prodotti agrochimici.
Grazie a misure gravimetriche e sensori di precisione, PlantArray® fornisce in tempi rapidi dati accurati su crescita, traspirazione, conduttanza stomatica, efficienza d’uso dell’acqua delle piante.
I principali vantaggi:
- Screening rapido e ad alta risoluzione: monitoraggio continuo e simultaneo di numerose piante, con dati riproducibili e non invasivi.
- Analisi in tempo reale: attraverso il software SPAC Analytics, è possibile personalizzare i trattamenti e interpretare le risposte fisiologiche durante lo svolgimento dell’esperimento.
Vuoi sviluppare il tuo prodotto con uno di questi servizi?
Contattaci per progettare insieme uno screening personalizzato
o per richiedere un test specifico con insetti, patogeni o nematodi.




